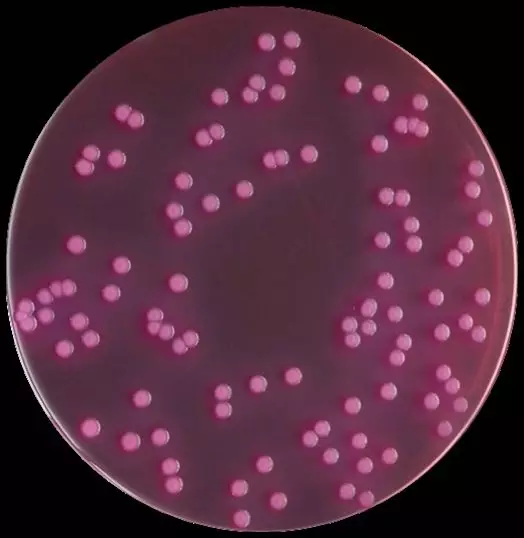
VRAB平板

GB4789.3-2016大肠菌群平板计数法细节解读
发布时间:2019-10-31 浏览次数:19304
1.所用器皿是否需要灭菌?
答:不需要。配制培养基所用到的锥形瓶、玻璃棒、勺子等均不需要灭菌,但要求一定要清洗干净,表面无污渍、无残留,且晾干无水渍。煮沸完成后,取下锥形瓶,用一般用锡箔纸覆盖瓶口,用橡皮筋缠绕,待冷却至适宜温度即可倾注培养基。在倾注培养基时,须点燃酒精灯,稍微灼烧锥形瓶口。
2.如何保持培养基“煮沸2min”?
答:培养基加热煮沸至完全溶解一般采用电陶炉或电热炉进行,但培养基很难保持煮沸2min,一旦煮沸,则培养基很快上涌、翻腾,若不调低温度或立刻采取其他措施,则培养基可在数秒内喷涌出来,严重者可喷涌2米以上、电磁炉周围1—2米范围内都是培养基飞溅的范围(实验室危险因子之一)。因此,要做到“煮沸2min”,则需在该培养基即将煮沸时调低温度,待培养基一沸腾就马上移离热源,待培养基停止沸腾后,又继续加热至沸腾状态又移开,这样间歇性煮沸2min。(注意规范操作,做好防烫措施,避免烫伤)
3.若培养基未用完,是否可以冷藏起来下次用?
答:不可以。4789.28中已规定,固体培养基最多允许熔融1次(指的是经过高压灭菌冷却后的培养基还可以熔融一次后使用)。且VRBA培养基冷却后,再次熔融时非常容易喷涌,若温度控制不当,底部培养基熔融后很快就会发生喷涌。
4.倾注完成后是否需要“覆盖一层”?如何覆盖?
答:需要覆盖。因为培养基冷却后在表面容易形成一些冷凝水,菌落容易蔓延开,所以在倾注完成后,再覆盖一层培养基,则菌落不容易接触到水,这样不易形成蔓延菌落。在检验中最好都进行覆盖,最好是在原培养基已凝固或半凝固(不会发生晃动)时再倾注一层培养基(“一层”是指缓慢倾注培养基至培养基刚好能够覆盖整个平皿)。
二、如何确定培养基上长的是不是大肠菌群?
答:不要去管什么是大肠菌群的典型形态,建议新手们认真按照标准进行证实试验,此证实试验非常简单,每一次VRBA上有菌落生长都进行证实试验,如此往复3-4次,对于哪种形态才是大肠菌群已经能够了然于心了。建议平时多配一些BGLB肉汤管冷藏储存备用,需要进行证实试验时分分钟可以完成试验。
三、两个梯度都长了菌,如何选取?如何进行证实试验?菌落选取数量?
答:选取15-150CFU之间的平板(指的是VRBA平板上所有菌落数在此范围),挑取可疑菌落进行证实试验。详细举例说明:若有两个连续梯度的4个平板上菌落数均在15-150之间,则4个平板上的菌落都要挑取进行证实试验,实际操作时,可灵活操作,如:1:10的两个平板上的菌落数分别为120、123,1:100的两个平板的菌落数分别为16、18,严格来讲必须至少在每个平板上分别挑取5个可疑菌落、5个典型菌落进行证实试验。建议使用镍合金接种环(即传统的接种环,而不是一次性塑料接种环),因为VRBA上生长的菌落(无论典型或可疑)大部分长在底层、且菌落一般较大,被培养基覆盖,传统的接种环较细,用以刮去上层培养基较方便,挑取菌落也较方便。
确证试验注意:1).每种可疑菌落挑取5个,每个菌落放入1管GBLB管中;2)“产气者,记为大肠菌群阳性管”,就要求在实验前须认真筛选BGLB管,凡小导管中有气泡的GBLB管应先排去导管中的气泡再使用。
VRAB平板上典型大肠菌群菌落形态

BGLB确证阳性结果
四、结果如何计算?
答:首先,在VRBA培养24h后进行计数,分别计数可疑大肠菌群和典型大肠菌群的数量。例:10-4样品稀释液1mL,在VRBA平板上有100个典型和可疑菌落,挑取其中10个接种BGLB肉汤管,证实有6个阳性管,则该样品的大肠菌群数为:100*6/10*104/g(mL)=6.0*105 CFU/g(mL)。若所有稀释度(包括液体样品原液)平板均无菌落生长,则以小于1乘以最低稀释倍数计算。
五、若所选适合计数梯度平板上可疑和典型菌落,最终证实全部为阴性,结果如何计算?
答:根据第3条,选取适宜菌落数的平板挑取菌落进行证实试验,若证实全部为阴性,则需要再挑取更低稀释度的平板上的菌落(建议可疑和典型菌落分别挑取10个)进行证实试验,若第二次证实试验均呈阴性,以<1乘以最低稀释度进行计算,如:1:10的平板菌落数分别为120、123,1:100的平板上菌落数分别为16、18,首先挑取1:100的两个平板上的菌落进行证实试验,若全部为阴性,再挑取1:10的两个平板上的菌落进行证实试验,若1:10的平板上的菌落数证实为阴性,则最终计算过程为<1x10,最终结果为<10;若1:10的的平板上的菌落有阳性管,则按照第5条进行计算。






